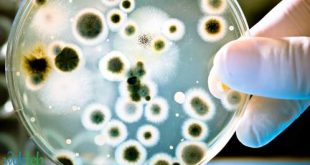

دعا وزير الاتصال, محمد لعقاب القنوات التلفزيونية الجزائرية إلى الارتقاء بأداء الإعلام العمومي وبث برامج تلفزيونية هادفة تحمل رسائل ومضامين جامعة للعائلة خلال شهر رمضان الكريم. وخلال سهرة ترويجية للشبكة البرامجية للمؤسسة العمومية للتلفزيون الجزائري بالمدرسة العليا للفندقة و الاطعام بعين البنيان، شدد وزير الاتصال, على ضرورة “الارتقاء بأداء الإعلام العمومي بصفة عامة و التلفزيون الجزائري بصفة خاصة, وذلك من …
اقرأ المزيدصحراء نيوز : وسم الارشيف
حاسي رمل: اطلاق المرحلة الثانية من “بوستينغ 3” نهاية 2026
كشف المدير الجهوي لمجمع “سوناطراك” بمنطقة حاسي رمل، يوسف لوصيف، عن الشروع في دراسة المرحلة الثانية من مشروع “بوستينغ 3″، لرفع ضغط الغاز ومواصلة الإنتاج على المديين المتوسط والبعيد. وأكد يوسف لوصيف، اليوم الأحد، في تصريحات للإذاعة الوطنية، الشروع في دراسة المشروع المكمّل، وهو المرحلة الثانية من مشروع “بوستينغ 3” على أن تتم عملية إطلاقه في نهاية 2026. وأوضح أن …
اقرأ المزيداكتشاف “بكتيريا قاتلة”في الصين
اكتشف العلماء نوعًا جديداً من البكتيريا الإشريكية القولونية، والتي تعد واحدة من السلالات شديدة العدوى البارعة في مقاومة المضادات الحيوية، وذلك بعد تفشيها بين الأطفال بالمستشفيات الصينية. وكشف تحليل تم إجراؤه في مختبرات جامعة “برمنغهام” البريطانية، أن السلالة الجديدة التي تحمل اسم “B5/H24RxC”، قادرة على النمو بمعدل أسرع وإلحاق المزيد من الضرر بالكائنات الحية مقارنة بالإصدارات السابقة. وجاءت هذه النتائج …
اقرأ المزيدتندوف: المنطقة الحرة للتبادل التجاري والصناعي ستكون بوابة نحو إفريقيا الغربية
أكد وزير التجارة وترقية الصادرات الطيب زيتوني اليوم الخميس بتندوف أن المنطقة الحرة للتبادل التجاري والصناعي ستكون بوابة نحو إفريقيا الغربية. وأوضح السيد زيتوني في تصريح للصحافة على هامش زيارة عمل قام بها إلى الولاية, أن “المنطقة الحرة للتبادل التجاري والصناعي “المقار” بولاية تندوف ستكون بوابة نحو إفريقيا الغربية”, مشيرا الى أن هذه الزيارة الميدانية تندرج في إطار “التحضير لفتح …
اقرأ المزيدالأدوية المصنعة محليا تتعرض ل “حملة شرسة” من مخابر أجنبية
قال وزير الصناعة والإنتاج الصيدلاني، علي عون، يوم الخميس بالجزائر العاصمة، أن كل الأدوية المصنعة في الجزائر و بالأخص الجنيسة ذات جودة عالمية، مما جعلها تتعرض “لحملة شرسة مؤخرا من طرف بعض المخابر الأجنبية”. وأكد، علي عون، خلال جلسة علنية خصصت لطرح الاسئلة الشفوية، بمجلس الأمة أن قطاعه “يقاوم حاليا حملة شرسة من طرف بعض المخابر الاجنبية ضد الأدوية المصنوعة …
اقرأ المزيد«كأس أفريقيا»: 6 منتخبات حسمت تأهلها رسميًا إلى الدور ربع النهائي
حسمت 6 منتخبات تأهلها رسميًا إلى الدور ربع النهائي لبطولة كأس أمم إفريقيا 2023، وذلك قبل مباريات اليوم الأخير من دور الـ16 بالبطولة القارية المقامة حاليًا في كوت ديفوار. وتأهل إلى الدور ربع النهائي لبطولة كأس أمم إفريقيا منتخبات (أنجولا – نيجيريا – غينيا – الكونغو الديمقراطية – كوت ديفوار – الرأس الأخضر)، ويتبقى بطاقتين من مواجهتي مالي ضد بوركينا …
اقرأ المزيدكان 2024: السنغال تودع المنافسة إثر خسارتها أمام كوت ديفوار بركلات الترجيح
فاز منتخب كوت ديفوار على حساب نظيره السنغال فى المباراة التي أقيمت بينهما مساء الإثنين، على ملعب “شارليس كونان باني” ضمن منافسات دور الـ16 من بطولة كأس الأمم الأفريقية المقامة حاليًا وتستمر حتى 11 فبراير القادم. وحققت ساحل العاج إنجازا كبيرا بفوزها في ياموسوكرو على منتخب السنغال حامل اللقب في ثمن نهائي كأس الأمم الأفريقية لكرة القدم ببركلات الترجيح بنتيجة …
اقرأ المزيدإدارة الحرب وتنظيمها.. مطلبٌ أمريكي وتنفيذٌ إسرائيلي
مخطئ من يظن أن الإدارة الأمريكية تريد وقف العدوان الإسرائيلي على قطاع غزة، أو أن ضميرها قد استيقظ من سباته واستفاق من غفلته، ولم يعد منحازاً كما كان، أو متواطئاً كما عرفنا، أو شريكاً كما ظننا، وأنها أصبحت إنسانية عاقلة تشعر بالآخرين وتحترمهم، وتعترف بالأعراف والقوانين، وتلتزم العهود والمواثيق، وترفض الظلم وتنشد العدل، وتسعى جادةً ومخلصةً لإنهاء الحرب التي يشنها …
اقرأ المزيداستشهاد عاهد أبو ستة صاحب الصرخة الشهيرة “ولّعت”
تداول ناشطون على مواقع التواصل خبر استشهاد الشاب الفلسطيني عاهد عدنان أبو ستة صاحب الكلمة الشهيرة “ولّعت” أثناء مقاومته لجيش الاحتلال الاسرائيلي في قطاع غزة. وكان الشهيد قد ظهر في مقطع فيديو قبل أسابيع بعد تدميره دبابة إسرائيلية وهو يقفز فرحا صارخا: “ولعت”، في إشارة لاحتراق الدبابة. وقالت مصادر محلية إن أبو ستة استشهد بعد قصف الاحتلال مجموعة من الأهالي …
اقرأ المزيدغرداية_ “قصر تافيلالت” يفتك المرتبة الأولى في جائزة الطاقة العالمية بالنرويج
توجت مؤسسة “أميدول” صاحبة مشروع المدينة البيئية المعروفة ب “قصر تافيلالت” بولاية غرداية, مؤخرا, بالمرتبة الأولى في جائزة “الطاقة العالمية” لسنة 2023 بالنرويج. وتعد جائزة الطاقة العالمية, التي احرزتها المدينة البيئية المعروفة ب “قصر تافيلالت” في هذه المسابقة التي شهدت مشاركة أزيد من 2000 مشروع يمثلون 180 دولة بالنرويج, من أبرز الجوائز البيئية المرموقة في العالم, حيث تهدف إلى تشجيع …
اقرأ المزيد صحراء نيوز موقع اخباري جزائري
صحراء نيوز موقع اخباري جزائري